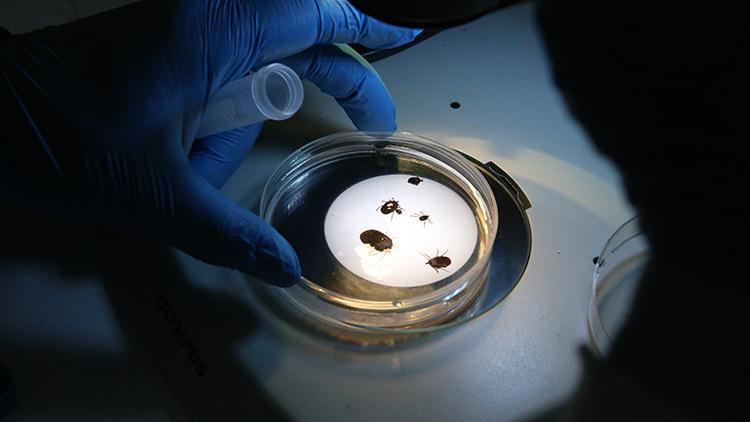

Türkiye’de yeni kene türü tespit edildi. Türkiye’deki 56. tür olarak kayıtlara geçen kenenin 30’dan fazla hastalık taşıdığı ve Uzak Doğu kökenli olduğu belirtiliyor.
Tokat Gaziosmanpaşa Üniversitesi (TOGÜ) Fen-Edebiyat Fakültesi Biyoloji Bölüm Başkanı Prof. Dr. Adem Keskin, Türkiye’de 56. tür olarak “Haemaphysalis longicornis” adlı yeni bir kene türünün varlığını tespit ettiklerini bildirdi. Prof. Dr. Keskin, Japon Ormancılık ve Orman Ürünleri Araştırma Enstitüsü Yaban Hayatı Ekolojisi Bölümünden Dr. Kandai Doi ile bir süredir Türkiye’deki keneler üzerine ortak çalışma yürüttüklerini söyledi.
Geçen yıl İstanbul’da bir kişinin üzerinde bulduğu bir keneyi kendilerine getirdiğini belirten Keskin, “Muhtemelen Çin menşeli bir kene. Ülkemize yerleşmiş olduğunu düşünüyoruz” dedi.
İstilacı bir tür olan bu keneye dikkat edilmesi gerektiğine işaret eden Keskin, “Bu türün Türkiye’ye 3-4 yıl önce geldiğini düşünüyorum. Sahada eylül ayından bu yana düzenli olarak aynı bölgeden örnekler topluyoruz. Bu süreçte kenenin larva, nimf (yetişkin forma benzeyen) ve ergin dişi evrelerini gözlemledik. Bu da bu türün ülkemizde yerleştiğini ve üremeye başladığını gösteriyor” ifadelerini kullandı.
Keskin, türünün hastalık taşıma potansiyeline ilişkin şu bilgileri verdi:
“Bu kenenin, Hyalomma marginatum gibi yüksek vektör potansiyeline sahip, 30’dan fazla hastalık etkenini taşıdığı biliniyor. Şu anda popülasyonunu takip ediyoruz. Üniversitemizin ve rektörlüğümüzün desteğiyle yürüttüğümüz proje kapsamında hem kenenin popülasyonunu izliyoruz hem de taşıyabileceği potansiyel patojenlerin varlığı ve yaygınlığı üzerine çalışmalar yapıyoruz. Bu çalışmada Dr. Kandai Doi de yer alıyor. Çalışmaları birlikte sürdürüyoruz. Ülkemizdeki türü sayısı 56 oldu ancak bazı türlerin isimleri, yapılan moleküler çalışmalar sonucunda değişebilir. Bu çalışmaların sonuçlarını bekliyoruz.”
Dr. Kandai Doi ise yeni tespit edilen kenenin bir Asya türü olduğuna dikkati çekerek, “Türkiye’de ilk kez tespit edilmiş olmasını kayıt altına aldık. Özellikle Çin ve Avustralya’da yaygın olarak görülüyor. 2017 yılından sonra ABD’ye de ulaştı. Burada hayvan hastalıkları açısından ciddi sağlık sorunlarına yol açtı. İstilacı bir tür olarak insan sağlığı açısından büyük risk taşıyor. 30’dan fazla hastalık etkenini taşıyabiliyor” diye konuştu.